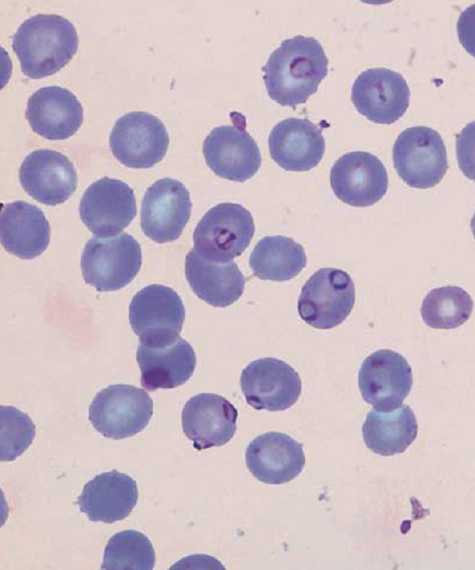
Ryan Reynolds - Wade / Deadpool
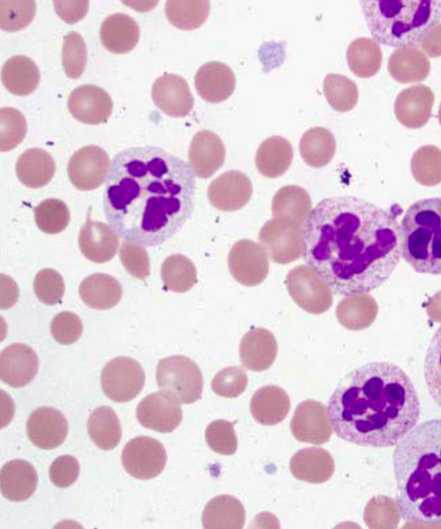
Gina Carano - Angel Dust

Alexa Gerald
Bullis School
Class of 2023

Read more about Alexa here.
Diagnosed a real patient from the Nagari Medical Clinic & Maternity Ward in Bauchi State, Nigeria.
Developed a public health campaign for communities in Sub-Saharan Africa for implementation in 2022.
Demonstrated mastery during clinical skills training in phlebotomy, ultrasound, and intubation procedures.


Read more about Alexa's achievements here.
Alexa Gerald is thrilled that she will be participating in the Advanced Medical & Public Health Internship this summer. She is excited to have the opportunity to be able to learn about how the healthcare system works and gain valuable experience diagnosing patients through the National Institute of Health and Howard University Medical School partnerships. Through her participation in the program, Alexa hopes to be able to develop a deeper knowledge of the various areas of study within the healthcare system.
As a rising senior at the Bullis School, Alexa is a dedicated student who is currently enrolled in several Advanced Placement Courses and is a member of both the National Honor Society and Science National Society. Most recently Alexa was inducted into and elected secretary of the English National Honor Society at her school. Additionally, Alexa is a part of her school's varsity lacrosse, and swim teams and serves as a member of her school's Black Student Union. In her spare time, Alexa volunteers with We Are Family DC which helps meet the needs of the elderly by delivering groceries to elderly residents of the District of Columbia and the DC Area Diaper Bank helping to provide formula, diapers, and feminine products to moms and babies throughout the Washington Metropolitan area.
Alexa hopes to study Biomedical engineering and eventually pursue a career in sports medicine. Alexa has always been interested in STEM and engineering as well as wanting to pursue a career in the medical field. In her role as both an athlete and a student, Alexa has learned about the workings of the body and how an athlete's recovery and health can impact their performance. Since Alexa has been in a sports environment throughout her life, she would like to work in the field of sports medicine as a team physician and work with athletes on professional sports teams while discovering new methods of athletic recovery.

In Partnership With The Nagari Medical Clinic & Maternity Ward In Bauchi State, Nigeria
The Advanced Medical & Public Health Internship diagnosis is the first-ever program of its kind. I not only got to work with the top medical professionals from around the world, but also save lives.
Through telemedicine, I was connected with a clinic and maternity ward in Bauchi State, Nigeria where I was able to interact with my patients in real-time. Supervised by a doctor in Nigeria, I examined & diagnosed my patient using my diagnostic training on the top 4 leading causes of death in Nigeria; malaria, typhoid fever, nutritional anemia, & acute respiratory infections (ARI).
These patients were locals from Bauchi State that were all ill and would normally not be able to afford medical treatment as they earn $1.25 a day or less. In return for working with our participants, all of their treatments were funded by Leadership Initiatives.
In 2022, Leadership Initiatives was able to fund the treatment of all patients participating in this program.
My Diagnosis


My Patient's
Diagnosis

Hauwa'u Mu'azu is an 18 year old living with her parents and attending school. She had a heart rate of 100 beats per minute. Additionally, Hauwa'u presented with an active fever, abdominal pain, headache, constipation, loss of appetite, and weakness.
After running the appropriate diagnostic tests, I concluded that Hauwa'u was suffering from malaria and typhoid. To treat the malaria, I prescribed CoArtem and to treat the typhoid, I prescribed an IV antibiotic.
In addition to these treatments, I recommended various methods of prevention for each disease. To prevent future cases of malaria, I suggested that the patient avoid mosquito bites through clothing, like long sleeves and pants, mosquito nets, and malaria prevention drugs, if accessible. For typhoid, I emphasized the importance of hygiene and sanitation practices, like hand washing.

I learned about four of the most pertinent diseases in the developing world from medical professionals including Dr. Aisha Garba-Aliyu, medical doctor and public health expert in Nigeria.
I developed cultural competencies and a global perspective to assess the structural and social determinants of health that underlie these diseases.
I had the unique opportunity to learn about and practice patient examination, evaluation, and diagnosis skills which contributed to the expansion of my preparedness for a future in the medical field.
As a group, we explored the historical, ethical, and cultural implications as well as the medical terminology and procedures pertaining to each of the 4 diseases.
I now have the skills to recognize, diagnose, and recommend both treatment and prevention methods for each of the four diseases.
I gained a better understanding of the signs and symptoms correlated with different stages and severities of Malaria, Typhoid Fever, Acute Respiratory Infection, and Nutritional Anemia.
My Public Health Campaign


Leadership Initiatives is a 501(c)(3) nonprofit organization that is dedicated to creating future leaders across the globe through experiential learning.
At the conclusion of the internship, I presented my research proposal to a panel of judges including Dr. Aisha Garba-Aliyu and Umar Muhammad.
View my public health campaign presentation here.
In the Advanced Medical & Public Health Internship, I worked directly with development and public health experts to create an education public health campaign. This campaign will target underserved communities in Nigeria and will be published and widely distributed in the area to increase awareness.
My Public Health Campaign Presentation
Phlebotomy
I learned how to draw blood using a phlebotomy arm simulator. Using this simulator allowed me to practice placing a needle in a vein to draw blood with realistic tissue-like material that imitates vein-wall resistance.
During this exercise, the medical facilitator instructed me on the proper technique and helped me improve the communication skills that I will use with future patients.
Intubation
I also worked with EMT instructors to learn how to perform multiple times of emergency resuscitation techniques including a manual esophageal intubation and a manual resuscitation airway mask.
The EMT helped me understand the proper situations to utilize different resuscitation and breathing assistance techniques and the proper equipment needed.
1
2
3
Clinical Skills Training



Laparoscopy
I learned about laparoscopy, which is a minimally invasive operation that allows physicians to observe and assess the abdomen or pelvis using small incisions and camera. It is an invaluable tool for developing diagnoses and interventions.
Once I was familiarized with the function of this technology, I had the unique opportunity to apply this knowledge to perform a simulated laparoscopy.
Internship Highlights
Experts & Mentors
Diagnostic Training
Nigerian Medicine
Suturing
Triage

I heard from top medical professionals in a variety of fields and specialties including surgery, emergency medicine, and medical research.
Mitchell Kannry, Fire Marshal at DC. Fire and EMS, spoke to us about careers in emergency response and how field medicine is done when trauma is involved.
Dr. Rachel Selekmen, a pediatric urologist and telehealth specialist., also spoke to us about her career trajectory, her studies, and a day in her life as a surgeon at Children’s National Hospital in DC.
Additionally, I had the unique opportunity to speak to leading public health experts and researchers at the National Institute of Health. Their knowledge helped guide me to determine the focus of my public health campaign.
By working with experts, I gained a better understanding of the responsibilities associated with each medical specialty and how to go about pursuing those particular careers.

Dr. Garba-Aliyu taught a series of workshops that demonstrated the proper way to interview a patient and explained various techniques to investigate disease.
Throughout the internship, I developed skills in the collection, interpretation, and critical analysis of patient data.
With Dr. Garba-Aliyu's guidance, I was able to improve my ability to synthesize and evaluate information, which is essential in the diagnostic process.
These exercises helped me advance my communication skills to appropriately evaluate patients and best understand their symptoms.

Through interactive educational seminars, I got an insight into the history of medical practices in Nigeria.
Dr. Garba-Aliyu provided me with the current practices in Nigerian medicine and a rich understanding of the growing mistrust of Western biomedical medicine in the region.
By meeting with actual patients, I gained insight into the lives of people living in Nigeria.
Understanding the lived experiences of these individuals allowed me to gain a critical perspective of what practices I could implement into my campaign to reduce the spread of infectious disease.

In one of the leading interactive activities of the internship, I learned and practiced multiple suturing techniques on a human-skin model.
While working on suturing, I employed instruction from medical professionals on the varying techniques and forms of suturing.
This activity provided insight into the primary tasks required of doctors and nurses, while also learning about some of the more intricate parts of medicine.
Along with suturing, I also practiced making plaster casts and other medical procedures. All of these activities helped prepare me for a career in medicine and strengthened my interest in the field.

Through the internship, I acquired basic clinical skills including taking vital signs, evaluating symptoms, and performing neurological exams.
When discussing vitals signs, we explored different methods of taking pulse. After demonstrating competency using each method, I am confident in my ability to calculate heart rate in any patient.
When performing neurological exams, we utilized a procedure that assesses the twelve cranial nerves. These nerves help facilitate normal and healthy bodily functions, and it is critical to evaluate their function in triage.
Along with these basic procedures, I had the opportunity to learn specialized skills like suturing and plaster casting.




